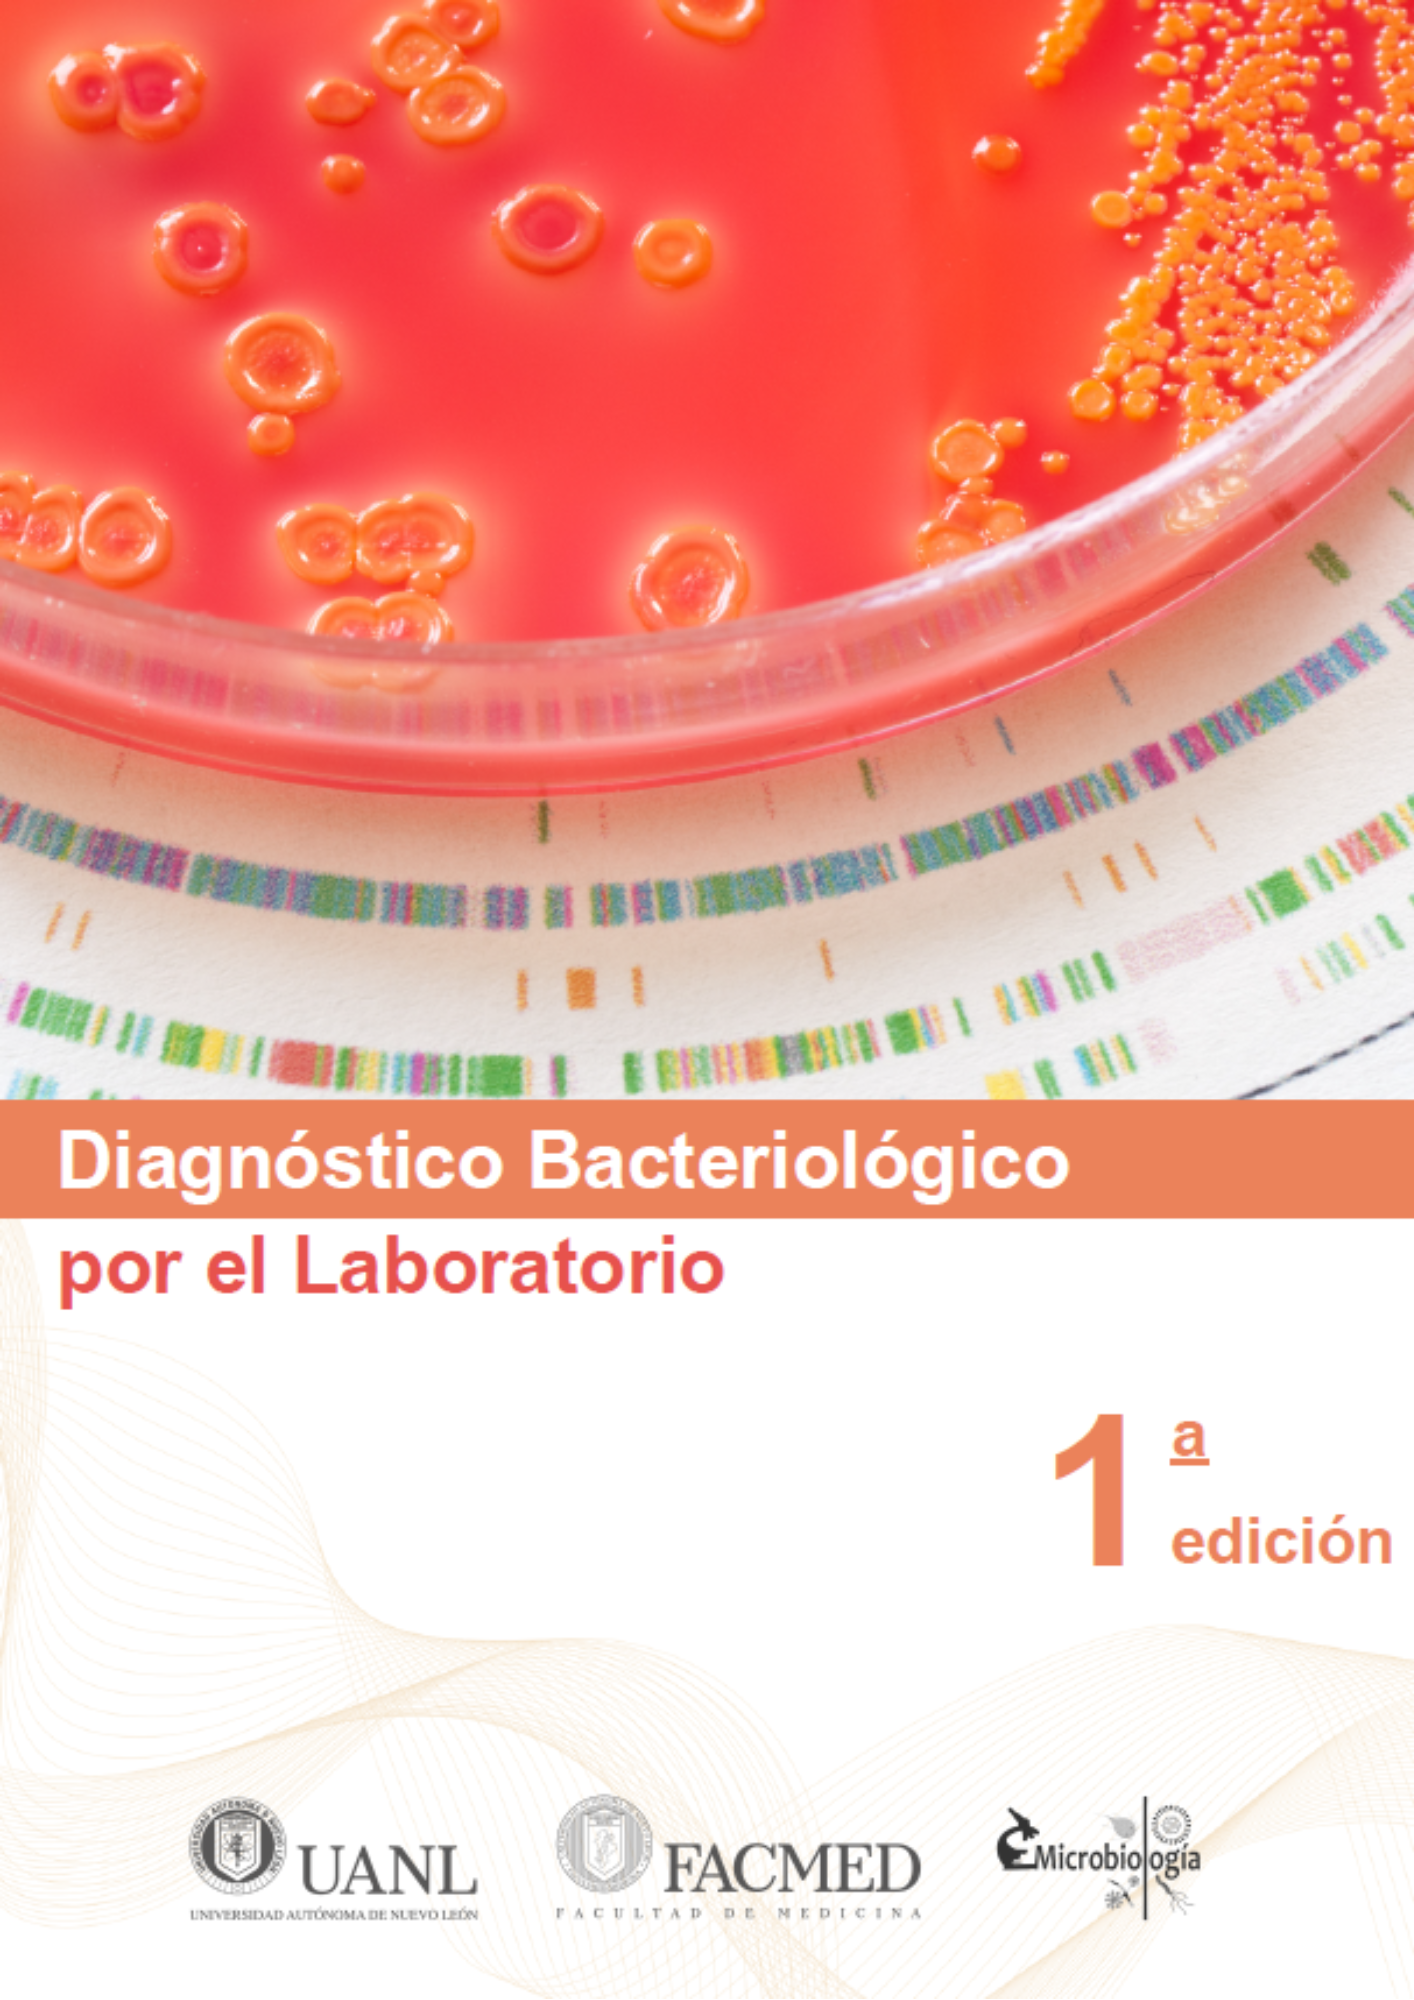

¡Tu carrito está actualmente vacío!
Diagnóstico Bacteriológico por el Laboratorio
Versión digital en PDF del manual «Diagnóstico bacteriológico por el laboratorio». Una guía práctica y completa para la identificación de bacterias de importancia médica en el laboratorio clínico. Ideal para estudiantes y profesionales de Química Clínica, Medicina y Microbiología. ¡Descarga inmediata!
Descripción
Diagnóstico Bacteriológico por el Laboratorio (versión digital – PDF)
Tu guía digital para comprender y aplicar las principales técnicas del diagnóstico bacteriológico clínico.
Este manual digital, elaborado por el Departamento de Microbiología de la Facultad de Medicina de la UANL, ofrece una sólida base teórico-práctica para la identificación de bacterias de importancia médica en el laboratorio clínico. Está diseñado para estudiantes y profesionales de la salud que deseen fortalecer sus habilidades en microbiología, a través de protocolos actualizados, esquemas interpretativos y ejercicios guiados que simulan situaciones reales de diagnóstico.
📘 Contenido del libro:
- Principios generales del diagnóstico bacteriológico: tipos de muestras, medios de cultivo, coloraciones y bioseguridad.
- Aislamiento e identificación bacteriana mediante pruebas bioquímicas clásicas y comerciales.
- Capítulos especializados sobre cocos Gram positivos y negativos, bacilos entéricos, no fermentadores y microorganismos fastidiosos.
- Evaluación de sensibilidad a antimicrobianos con base en métodos estandarizados (Kirby-Bauer).
- Tablas comparativas, esquemas de flujo, algoritmos de diagnóstico y formatos para el reporte de resultados.
- Actividades prácticas diseñadas para consolidar el aprendizaje y desarrollar el razonamiento clínico-microbiológico.
💻 Ventajas de la versión digital:
- Acceso inmediato tras la compra.
- Consulta desde computadora, tablet o smartphone.
- Imprimible por secciones para uso práctico en el laboratorio.
- Compatible con cualquier lector de archivos PDF.
🎯 Dirigido a:
Estudiantes de Química Clínica, Medicina, Bacteriología, Técnicos laboratoristas, docentes y profesionales del área de microbiología que buscan un recurso claro, completo y enfocado a la práctica diagnóstica bacteriológica.
📄 Formato:
Archivo digital en PDF | 160 páginas | Descarga inmediata